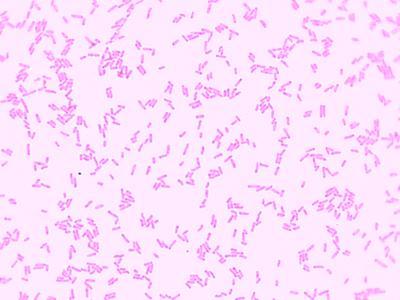

E.Coli (Sm) G(-) Found In Human ,Each
$ 6.79
|
|
Details:
E.COLI (SM) G(-) FOUND IN HUMAN
Additional Information
| SKU | 23377737 |
|---|---|
| UOM | EACH |
| UNSPSC | 60100000 |
| Manufacturer Part Number | WARD470177-410 |
| Product Dimensions | 3X0.05X1 Inches |
| Product Weight | 0.05 |
